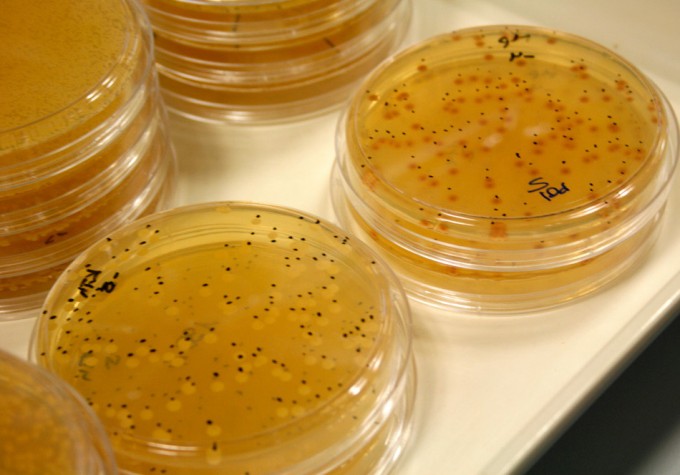
Mapa genético de la levadura del vino

Según una investigación desarrollada por expertos del Instituto de Investigación del Vino de Australia (Australian Wine Research Institute), organización que investiga el mundo de la uva y el vino que se produce en Australia, los genomas de la levadura del vino carecen de diversidad genética y cuentan con un alto nivel de endogamia. Esta es la conclusión que se desprende tras la secuenciación del genoma de cientos de cepas de levaduras.
Los investigadores explican que en muchos casos las cepas de levadura que son comercializadas por distintas empresas son prácticamente idénticas a nivel genético, por lo que se sugiere que los productores de vino que intentan desarrollar la mejora de sus levaduras, van a tener que intentar desarrollar levaduras híbridas con diferentes cepas. Para elaborar vino es necesario contar con un tipo de levadura que sea mucho más tolerante al estrés que las cepas habituales que se utilizan en la industria cervecera, debe ser capaz de soportar los elevados niveles de acidez y azúcar presentes en el zumo de la uva.
Según los resultados obtenidos, sólo una rama de la familia de la levadura Saccharomyces cerevisiae es utilizada actualmente en la elaboración de vino. Las levaduras contribuyen en el sabor final de los vinos y pueden proporcionar un componente de “terroir”, es decir, un vino único por sus condiciones y componentes locales. Tradicionalmente el vino ha sido fermentado por levaduras de origen natural, pero es una práctica que puede derivar en resultados inconsistentes, variando de una vendimia a otra. Por ello, para obtener resultados predecibles, que los vinos tengan las mismas características y sabor, la mayoría de productores de vino utilizan levaduras secas como levaduras de arranque que han sido producidas por proveedores comerciales, como ya hemos comentado antes, las que comercializan la mayoría de empresas son prácticamente idénticas a nivel genético.
Según los datos obtenidos a partir de la secuenciación genética de la levadura Saccharomyces cerevisiae, prácticamente todas las levaduras del vino están estrechamente relacionadas a nivel genético, apenas contienen una pequeña fracción que las diferencia. Los expertos consideran que prácticamente todas derivan de un ancestro común o de una población ancestral endogámica. Apuntan que las cepas que comercializan diferentes empresas prácticamente no se diferencian a nivel genético, hay que decir que se secuenciaron 212 cepas de la levadura mencionada, además de las comerciales, cepas aisladas de fermentaciones naturales, cepas utilizadas en la elaboración de cerveza y otras bebidas alcohólicas basadas en el vino.

Esas diferencias mínimas a nivel genómico pueden ser responsables de las propiedades de fermentación y sabores únicos, de lo contrario, prácticamente todos los vinos que se desarrollaran con las diferentes cepas de la mencionada levadura se parecerían bastante. Hay que decir que también se han encontrado cepas con un perfil genético muy distinto, concretamente en cuatro cepas que integran un conjunto de genes únicos que están implicados en la producción de una clase específica de elementos químicos aromáticos, en otros casos, algunas cepas parecen haber derivado de la hibridación de cepas de levaduras que no se utilizan para la elaboración de vino, ya que algunos genes se asocian a las levaduras que se utilizan para la producción de cerveza.
Pero a pesar de estas pocas variaciones, a nivel general se puede decir que existe muy poco margen para poder crear nuevas cepas a partir exclusivamente de las levaduras del vino, por ello se considera que se deberá llevar a cabo la hibridación con otras cepas, como por ejemplo las de las fermentaciones naturales del “vino” de palma, una bebida alcohólica similar al vino y otras cepas procedentes de la elaboración de variedades de cerveza japonesa, ya que son portadoras de genes que no están presentes en las levaduras de vino y cerveza occidental.
Ahora los investigadores del AWRI (Australian Wine Research Institute) trabajan en el desarrollo de nuevas cepas de levaduras que permitan obtener distintos perfiles de sabor y aroma durante la fermentación del vino. La secuenciación genética de las levaduras es un recurso de gran interés, ya que proporciona una plataforma para llevar a cabo diferentes investigaciones genéticas para otorgar a los vinos resultantes determinadas características organolépticas o de fermentación. Además se podrán desarrollar vinos de mayor calidad y mucho más económicos, aspectos muy necesarios en este mercado que últimamente se ha hecho tan competitivo.
A través de este artículo publicado en la revista científica G3: Genes|Genomes|Genetics, podréis conocer todos los detalles sobre esta investigación.
Foto 2 | Winetitles columnist







